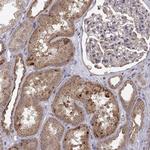
Abl2 Antibody in Immunohistochemistry (Paraffin) (IHC (P))

Search
Invitrogen
Abl2 Polyclonal Antibody
{{$productOrderCtrl.translations['antibody.pdp.commerceCard.promotion.promotions']}}
{{$productOrderCtrl.translations['antibody.pdp.commerceCard.promotion.viewpromo']}}
{{$productOrderCtrl.translations['antibody.pdp.commerceCard.promotion.promocode']}}: {{promo.promoCode}} {{promo.promoTitle}} {{promo.promoDescription}}. {{$productOrderCtrl.translations['antibody.pdp.commerceCard.promotion.learnmore']}}
产品信息
PA5-84910
种属反应
宿主/亚型
分类
类型
抗原
偶联物
形式
浓度
规格
纯化类型
保存液
内含物
保存条件
运输条件
RRID
产品详细信息
Immunogen sequence: SSSSVVPYLP RLPILPSKTR TLKKQVENKE NIEGAQDATE NSASSLAPGF IRGAQASSGS PALPRKQRDK SPSSLLEDAK ETCFTRDRKG GFFSSF
Highest antigen sequence indentity to the following orthologs: Rat - 88%, Mouse - 86%.
靶标信息
ABL2 (Arg) is an Abl-related non-receptor protein tyrosine kinase that links cell surface receptors to cell proliferation and/or cytoskeletal reorganization. Abl2 encodes a member of the Abelson family of nonreceptor tyrosine protein kinase. The protein is highly similar to the ABL1 protein, including the tyrosine kinase, SH2 and SH3 domains, and has a role in cytoskeletal rearrangements by its C-terminal F-actin- and microtubule-binding sequences. Abl2 is expressed in both normal and tumor cells, and is involved in translocation with the ETV6 gene in leukemia. Multiple alternatively spliced transcript variants encoding different protein isoforms have been found for this gene.
仅用于科研。不用于诊断过程。未经明确授权不得转售。
篇参考文献 (0)
生物信息学
蛋白别名: Abelson murine leukemia viral oncogene homolog 2; Abelson tyrosine-protein kinase 2; Abelson-related gene protein; arg tyrosine kinase; c-abl oncogene 2, non-receptor tyrosine kinase; FLJ22224; FLJ31718; FLJ41441; Tyrosine-protein kinase ABL2; Tyrosine-protein kinase ARG; v-abl Abelson murine leukemia viral oncogene homolog 2
基因别名: ABL2; ABLL; ARG
UniProt ID: (Human) P42684
Entrez Gene ID: (Human) 27